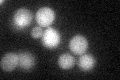
YHR029C
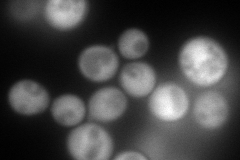
YHR029C
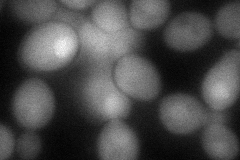
YHR029C
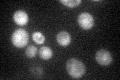
YHR029C

View description
Protein of unknown function; null mutant is defective in unfolded protein response; possibly involved in a membrane regulation metabolic pathway; member of the PhzF superfamily, though most likely not involved in phenazine production
Localization:
Intensity:
Fold change:
Significance:
-
C’ GFP library in SD
cytosol24.01 -
N' NOP1pr-GFP in SD
cytosol272.777 -
N' TEF2pr-mCherry in SD

cytosol0 -
N' NATIVEpr-GFP in SD

cytosol25.8648 -
N' TEF2pr-VC and Cyto-VN in SD
cytosol78.5522 -
C’ GFP library in SD+DTT

cytosol19.50.81No -
C’ GFP library in SD+H2O2

cytosol38.691.61Yes -
C’ GFP library in Starvation Media
cytosol51.382.13Yes -
C’ GFP library on the background of Pup2-DaMP

N/A -
C’ GFP library on the background of CCT mutant

N/A0N/AYes
